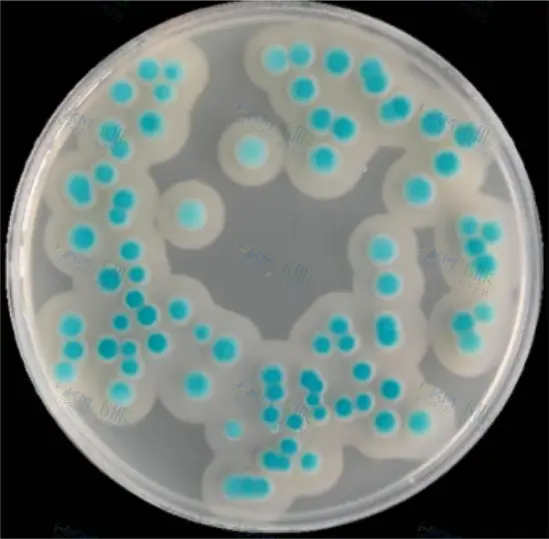
蜡样芽孢杆菌显色培养基菌落特征
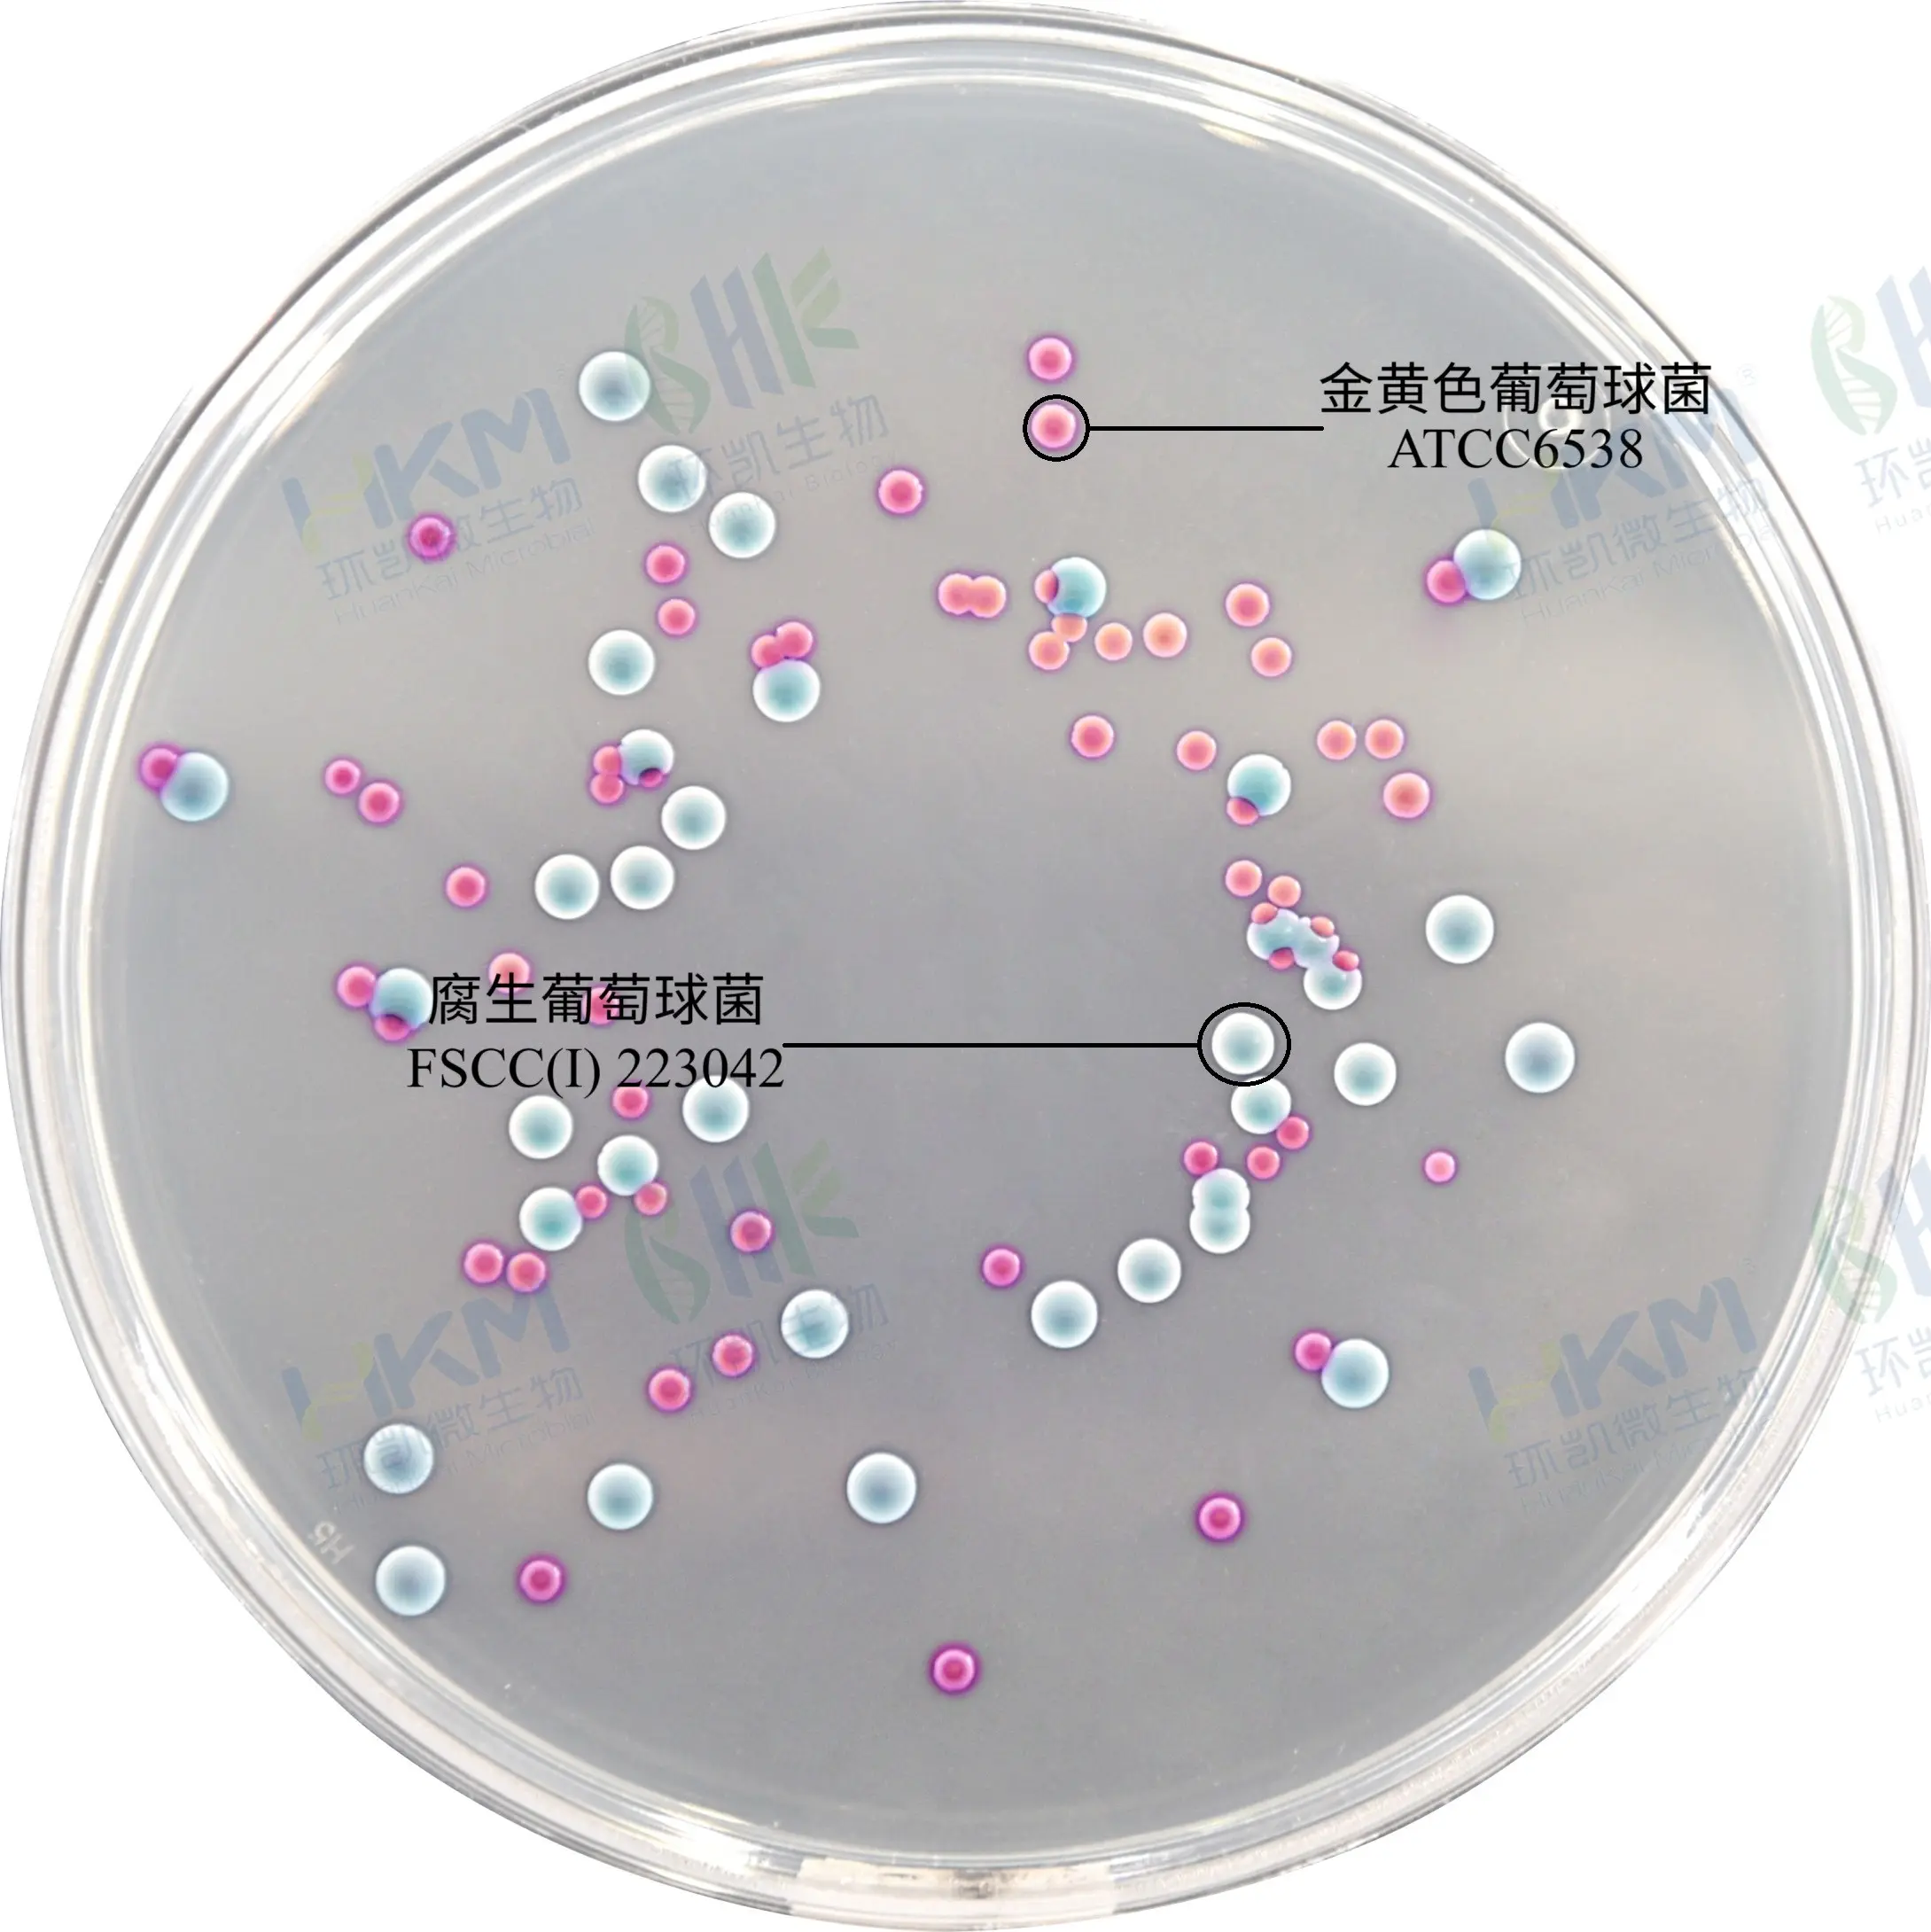
金葡菌显色培养基菌落特征
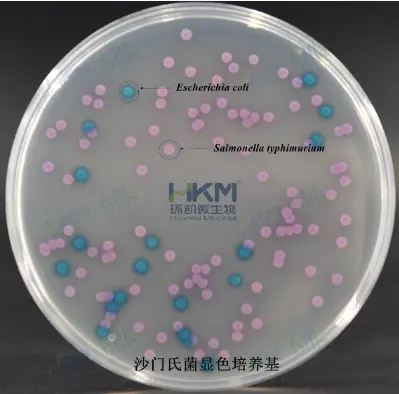
沙门氏菌显色培养基菌落特征

食源性致病菌菌落形态图谱:显色培养基特征鉴别指南(大肠杆菌/沙门氏菌/金葡菌等)
发布时间:2026-03-18 浏览次数:33
菌落形态的精准识别是食品微生物检测的基础核心环节,不同微生物在专用选择性培养基上,会呈现出极具辨识度的形态、颜色、光泽与边缘特征,这既是致病菌快速初筛、食品卫生状况判定的关键依据,也为后续生化鉴定提供了重要参考。本文将食品检测中常见的致病菌、指示菌、污染菌按形态+颜色+光泽+边缘四维度系统梳理菌落特征,搭配适配食品检测实操的专用生化鉴定培养基,为微生物快速筛查与鉴定提供标准化耗材支持,为食品微生物检测工作提供精准、高效的参考依据。
致病菌:食品安全核心筛查对象
致病菌是引发食源性疾病的主要元凶,我国食品安全国家标准对多数食品中致病菌实施“不得检出”管控,其菌落特征具有高度特异性,是检测识别的关键依据。
1、大肠菌群、大肠杆菌

这张平板用于区分大肠杆菌与其它大肠菌群。平板上分布着两类典型菌落:蓝-绿色菌落和紫红色菌落,分别对应大肠埃希氏菌和其它大肠菌群在该培养基上的显色反应。
- 蓝-绿色菌落:为大肠埃希氏菌(Escherichia coli)的典型表现,菌落呈圆形、边缘整齐、表面光滑湿润,颜色为蓝绿色或蓝灰绿色,大小中等,分布较均匀,部分区域有轻微聚集。
- 紫红色菌落:为其它大肠菌群(如克雷伯氏菌、肠杆菌属等)的典型表现,菌落形态与蓝绿色菌落相似,呈圆形、边缘整齐、表面光滑湿润,但颜色为紫红色或粉红色,大小中等,分布较分散。
环凯配套产品:CRM003 大肠菌群大肠杆菌显色培养基。
2、蜡样芽孢杆菌
这张平板用于蜡样芽孢杆菌的选择性分离和初步鉴别。平板上分布着典型菌落:蓝-绿色带白色晕圈菌落,符合蜡样芽孢杆菌在该培养基上的显色反应。
- 蓝-绿色带白色晕圈菌落:为蜡样芽孢杆菌的典型表现,菌落呈圆形、边缘整齐、表面光滑湿润,中心为蓝绿色,外围环绕一圈白色晕圈,大小中等,分布较均匀,部分区域有聚集现象。该显色反应基于蜡样芽孢杆菌特异性代谢酶与培养基中显色底物的反应,便于直接观察和鉴定。
- 其它杂菌:图中未见明显无色或绿色菌落,说明杂菌被有效抑制或未生长,符合该培养基的选择性设计。
环凯配套产品:CRM005 蜡样芽孢杆菌显色培养基。
3、金黄色葡萄球菌
这张平板上主要有两种菌落:金黄色葡萄球菌ATCC 6538和腐生葡萄球菌FSCC(I) 223042。图中分布着粉红色菌落,根据显色培养基的特性,这些粉红色菌落符合金黄色葡萄球菌在显色培养基上的典型表现。其菌落特征如下:
- 颜色:粉红色,这是金黄色葡萄球菌在特定显色培养基上因酶活性产生的典型颜色。
- 形状:圆形,边缘整齐,菌落大小中等,表面光滑湿润,凸起明显。
- 分布:菌落分散分布,部分区域有聚集现象,符合平板划线或涂布接种后的生长特征。
图中分布着白色菌落,这些白色菌落符合腐生葡萄球菌在显色培养基上的典型表现。其菌落特征如下:
- 颜色:白色,腐生葡萄球菌在显色培养基上通常不产生色素,呈现白色或无色。
- 形状:圆形,边缘整齐,菌落大小中等,表面光滑湿润,凸起明显。
- 分布:菌落分散分布,部分区域有聚集现象,符合平板划线或涂布接种后的生长特征。
环凯配套产品:CRM012 金葡菌显色培养基。
4、沙门氏菌
这张平板是沙门氏菌显色培养基,用于区分沙门氏菌与大肠杆菌。平板上分布着两种颜色的菌落:品红(紫红)色菌落和蓝绿色菌落,分别对应沙门氏菌和大肠杆菌在该培养基上的典型显色反应。
- 品红(紫红)菌落:符合沙门氏菌在沙门氏菌显色培养基上的典型表现。其菌落特征为圆形、边缘整齐、表面光滑湿润,颜色为品红(紫红)。
- 蓝绿色菌落:符合大肠杆菌在沙门氏菌显色培养基上的典型表现。其菌落特征为圆形、边缘整齐、表面光滑湿润,颜色为蓝绿色或绿色。
环凯配套产品:CRM004 沙门氏菌显色培养基。
5、单增李斯特氏菌

图中平板为单增李斯特氏菌显色培养基(CRM013),其上分布着两类菌落:蓝绿色菌落和白色菌落,分别对应单增李斯特氏菌与其他李斯特氏菌在该培养基上的典型显色反应。
- 蓝绿色菌落:为单增李斯特氏菌的典型表现,菌落呈圆形、边缘整齐、表面光滑湿润,颜色为蓝绿色或蓝灰绿色,大小中等,分布较均匀,部分区域有轻微聚集。
- 白色菌落:为其他李斯特氏菌(如默氏李斯特菌、绵羊李斯特菌等)的典型表现,菌落形态与蓝绿色菌落相似,呈圆形、边缘整齐、表面光滑湿润,但颜色为白色或无色
环凯配套产品:CRM013 李斯特氏菌显色培养基。
菌落形态观察与鉴定实操要点
1. 致病菌(细菌)的培养条件
温度与时间:
- 致病菌(如细菌)通常在 36℃±1℃ 下培养 24~48小时,符合常规要求:
- 细菌菌落(如大肠杆菌)在24小时内可见明显菌落,但部分生长缓慢的菌种(如某些厌氧菌)可能需要延长至48小时以观察完整形态。
注意事项:若培养时间不足(如<24小时),菌落可能未充分发育,导致形态特征(如边缘、隆起度)不典型,影响鉴别。
2. 霉菌和酵母菌的培养条件
温度与时间:霉菌:建议 25~28℃ 培养 5~7天。培养时间不足可能导致霉菌特征不完整(如孢子未形成、菌丝稀疏)。
所有培养需在无菌条件下进行,并使用专用培养基(如细菌用营养琼脂,霉菌用PDA培养基)。培养时应倒置平板,防止冷凝水影响菌落形态。某些耐低温霉菌(如冷藏环境样本)需在15~20℃培养,时间延长至7~10天。产色素的菌种(如曲霉)需充足时间以显色,否则易误判。
参考文献:[1]凌春榕,秦剑冉,牟康义,陈芳,胡小松,董丽.食源性致病菌快速检测方法的研究进展[J].食品安全质量检测学报,2025,v.16(16):100-112.
来源:微生物安全与健康网,作者~胡少芳。
